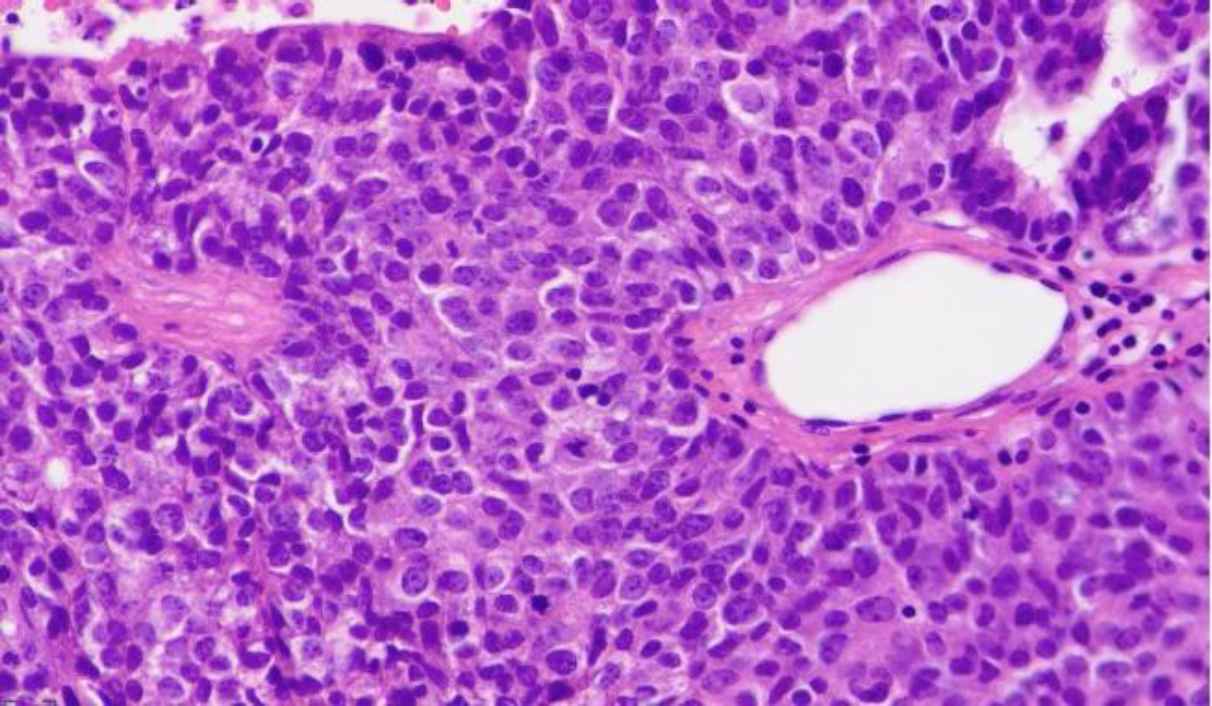

Introduction
Acinic cell carcinoma (ACC) is a rare malignant epithelial neoplasm of the salivary gland that occurs more frequently in the parotid gland. The incidence of ACC is slightly higher in women than in men, and the median incidence age is 52. Histologically, ACC shows multidirectional differentiation towards acinar, ductal as well as myoepithelial cells, although the acinar cell differentiation is the most characteristic element. Acinar cells are polygonal with lightly basophilic cytoplasm and diastase resistant periodic acid-Schiff (PAS-D) positive zymogen granules. The growth pattern may be predominantly solid, microcystic, papillary–cystic, or follicular (1-6). Radiation exposure and familial predisposition are possible risk factors for ACC (4, 7).
ACC is generally a low-grade malignant tumor; however, some variants with high-grade transformation or dedifferentiation are associated with late recurrence, metastasis, and aggressive behavior (6, 8, 9). The recurrence rate is about 35%, with a notable tendency for late recurrence, up to 30 years after the initial presentation. Metastases occur in about 12% of all ACCs, mainly through the hematogenous way. The most common sites are cervical lymph nodes, lungs, and bones. Other less common reported metastases are cavernous sinus, spine, sternum, orbit, liver, skin, and intracranial space (4, 6).
Stanley et al. reported the first case of dedifferentiated ACC from the parotid gland in 1988 (10). Since then, few cases of ACC with dedifferentiated components and aggressive behavior have been reported (11-13). This article reports a case of a parotid gland ACC with a dedifferentiated component and brain metastasis.
Case Presentation
Our case was a 49-year-old woman with a history of a right parotid painless mass lesion, which had grown 5-6 cm over eight months. Fine needle aspiration cytologic evaluation of parotid lesion was consistent with monomorphic adenoma, based on available cytologic reports from another center. The patient underwent a right parotidectomy at the same center. Histological examination indicated ACC with dedifferentiated components. Some adverse histologic factors, including more than two mitoses/10 HPFs, perineural/vascular invasion, tumor necrosis, and extracapsular invasion, were also identified on microscopic examination (Figure 1, A and B). The patient underwent t 30 sessions of radiotherapy. After two months, she experienced sudden severe left hemifacial paresis. Brain CT scan imaging demonstrated a 45*40 mm heterogeneous itrapa-renchymal cerebral hemorrhage in the right frontoparietal lobe with surrounding edema, which caused a 6 mm midline shift to the left side (Figure 2). She became a candidate for craniotomy at our center with the clinical impression of intracranial hemorrhage. Tissue samples were sent to the pathology department. Gross examination of the specimen showed multiple fragments of tanish gray soft fragile tissue. Microscopic study of the brain tissue showed a neoplasm composed of a mixture of different cell types, including most large polygonal cells with round to small oval nuclei, stippled chromatin pattern, and abundant basophilic granular cytoplasm. Some vacuolated cells and some cuboidal cells with eosinophilic cytoplasms and small dark nuclei were arranged in solid, follicular, and microcystic patterns (Figure 3 A and B). The cytoplasmic granules demonstrated diastase-resistant periodic acid-Schiff (PAS-D) positivity (Figure 4). Some foci were also observed with histologic features of the undifferentiated carcinoma, composed of atypical cells with pleomorphic nuclei, prominent nucleoli, and abundant mitotic figures (Figure 5). In the immunohistochemical study, tumor cells were positive for cytokeratin and showed DOG 1 positivity with apical membrane staining (Figure 6). Therefore, metastatic ACC with dedifferentiated components was diagnosed.

Fig. 1.Histologic examination of parotid gland mass. A) A neoplasm is composed of different cell types arranged in follicular and microcystic patterns. Most tumor cells are large polygonal with a round to small oval nuclei, stippled chromatin and abundant basophilic granular cytoplasm (H&E stain, 400X). B) Dedifferentiated component with a solid pattern showing nuclear pleomorphism and increased mitotic rate with small foci of tumor necrosis (lower left) (H&E stain, 400X)

Fig. 2.Brain CT scan. A heterogeneous intraparenchymal cerebral hemorrhage in the right frontoparietal lobe with surrounding edema

Fig. 3.Histologic examination of the brain lesion. A) A neoplasm showing the same histomorphologic features described in the previous parotid gland mass (H&E stain, 200X), B) Brain parenchyma with tumor invasion (H&E stain, 200X)

Fig. 4.PAS-D staining. The cytoplasmic granules demonstrate PAS-D positivity (400X)
Fig. 5.Histologic examination of the brain lesion. Foci of undifferentiated carcinoma with solid growth pattern showing nuclear pleomorphism and increased mitosis (H&E stain, 400X)

Fig. 6.IHC stain. Tumor cells were positive for cytokeratin (A) and showed DOG 1 positivity with apical membranous staining (B), (IHC 400X)
Discussion
Salivary gland tumors originate from the major or minor salivary glands, either benign or malignant. Most tumors occur in the parotid gland, but their malignancy potential is less than submandibular, sublingual, and minor salivary glands tumors (14).
ACC constitutes 1-6% of malignant salivary gland tumors and mainly occurs in the parotid gland (81-98%), followed by the submandibular gland (11%) and minor salivary glands (3-12%) (2, 7).
Patients with ACC typically present with a painless mass or swelling of the salivary glands (15). A solitary, encapsulated mass with a soft consistency and grey-white cut surfaces is usually seen on gross examination. Recurrent lesions are more commonly lobulated, may be unencapsulated, and show areas of necrosis. The acinar cell is the main histological differentiation of ACC. However, some other cell types, including intercalated ductal, vacuolated, clear, and non-specific glandular, are also recognized. The main growth patterns are solid-lobular, microcytic papillary-cystic, and follicular (4, 6, 15, 16). Complete surgical excision is the most effective treatment for acinic cell carcinoma. Postoperative radiation therapy may be helpful in cases with questionable margins, residual tumor after resection, and adverse pathologic characteristics, including a high tumor stage, neck node metastasis, high-grade transformation, perineural invasion, and lymphovascular invasion (17-19).
Most ACCs show a positive reaction for CK7 and CAM 5.2 in the IHC study. The tumor cells are commonly negative for p63 and CK20. DOG1 is expressed in normal serous acini and mucus acini (apical membranous staining pattern), and distal intercalated ducts (apical staining). Intense DOG1 expression, accompanied by the periodic acid– Schiff (PAS) reaction after diastase treatment, helps differentiate ACCs from morphologic mimics (20, 21).
Although ACC is overall a low-grade malignancy, it may show an unpredictable clinical course, especially regarding a subgroup of ACC described as “ACC with the dedifferentiated or high-grade transformation” (8, 9). Stanley et al. reported the first case of dedifferentiated ACC in 1988 (10). The high-grade transformation is also described in other salivary gland carcinomas such as adenoid cystic carcinoma and mucoepidermoid carcinoma (22, 23). The etiopathogenesis of the dedifferentiation and high-grade transformation is unknown (24).
"Dedifferentiation" is defined as an abrupt transformation of a well-differentiated tumor into a high-grade morphology, which lacks the histologic features of the primary conventional tumor. The conventional and high-grade areas are sharply demarcated; however, a transitional zone can be identified in some cases (24). The high-grade component is characterized by atypical cells with pleomorphism, prominent necrosis, and high rate of cell proliferation (Ki67 index). Recent large studies around the development and progression of salivary gland tumors suggested some genetic changes could be related to ACC. The results revealed a deletion in tumor suppressor genes such as CDKN2A, B and chromosomal alternation on 4p, 5q, 6p, and 17p. These molecular changes were associated with tumor development. Also, deletions of chromosome 6q, loss of Y, and trisomy 21 have been reported in some ACCs (25, 26). Of note, Ska'lova et al. reported that TP53 gene mutation and HER2 amplification had not been detected in nine examined cases of dedifferentiated ACC. All nine cases showed intense membrane staining for β-catenin in the high-grade component vs. mildly cytoplasmic and nuclear staining in the low-grade areas. Cyclin-D1 expression and Ki67 index were higher in the high-grade component than in the low-grade foci (9). Recently, Lauren et al. also confirmed abnormal Cyclin-D1 and β-catenin IHC staining in high-grade transformed ACC (8).
There is no WHO histologic grading system for the classification of ACC. Gomez et al. suggested the "proliferative grading system", which recognizes high-grade neoplasms only based on high mitotic rate [>2 mitoses/10 HPFs] and presence of necrosis (27). These data are similar to older studies (28, 29) and confirmed by recent studies (17, 30).
The reported recurrence rate of ACC is about 35%, and it mostly happens late – some reports show tumor recurrence, even after 30 years from the initial presentation (31). Metastases occur in 0-30% of ACCs and tend to be hematogenous rather than lymphatic (32, 33). The most common sites are the cervical lymph nodes, lungs, and bones. Although not common, other reported sites for metastases are cavernous sinus, spine, sternum, orbit, liver, skin, and intracranial space (1, 4, 6, 34). Based on the most recent literature, the main prognostic factors that may predict poor outcome and metastasis include extracapsular extension, facial nerve involvement, positive surgical margins as well as high pathologic grade as evidenced by >2 mitoses/10 high power fields, cellular atypia, necrosis, perineural and vascular invasion and desmoplastic stromal reaction (35, 36). Of note, Fang et al. suggested that high-grade transformation is an independent predictor factor of distant metastases in parotid ACC (37). Khelfa et al. reported a 78-year-old female with a history of right parotid ACC, which presented with pelvic metastasis one year after diagnosis (6). Vidyadhara et al. also reported a 40-year-old man presented with sudden-onset severe back pain and neurological signs such as tingling, numbness, and spasticity of both lower limbs. The patient had a previous history of incomplete parotid gland resection and was diagnosed with ACC through histological examination. Magnetic resonance imaging (MRI)of the spine revealed a mass lesion of the T4 vertebra. He underwent posterior decompressive laminectomy of T4 vertebra, and the Histopathological examination was conclusive of metastatic ACC (1). Al-Otaibi et al. reported a 48-year-old woman with histological diagnosis of ACC of the parotid gland with high-grade transformation, perineural invasion, positive surgical margins, and regional lymph node involvement. Less than a year later, the patient developed widespread distant metastases at multiple sites, including the brain, lungs, liver, bones, and retroperitoneum (38). Most of the reported cases were over 40 years old, similar to our case. In most patients, metastases occurred after 6-12 months from initial parotidectomy, while in our case, they occurred within two months. Most of the reported metastases were to the bones, lungs, and brain. Unfavorable factors such as extensive local invasion, positive surgical margins, lymph node involvement, and high-grade transformation were observed in the histologic examination of most reported parotid gland ACCs.
About our case, although histologic features were suggestive of poor prognosis, lymph node dissection while parotidectomy and IHC study for ki67 was not performed. Therefore, exact staging of the initial ACC of the parotid gland was not possible.
The reported prognosis and survival data are generally favorable, with a 10-year overall survival rate of >80% (27, 39), but Metastatic ACC has a poor prognosis with 5-year survival rates of less than 50% (40). Therefore, ACC should be considered a malignancy with an unpredictable clinical course due to its propensity to recur, metastasize and even lead to death, especially a subgroup described as "ACC with dedifferentiation or high-grade transformation" (41). Due to notably high tendency of latent recurrence and metastasis more than 20 or 30 years after initial treatment in ACC cases, long-term patient follow-up is mandatory.
Conclusion
We reported a rare case of brain metastasis of a parotid dedifferentiated ACC primary. Although ACCs are infrequently accompanying metastasis, in a patient with a history of ACC presented with new unexplained signs and symptoms, a metastatic lesion must be kept in mind as an important differential diagnosis. Therefore, long-term follow-up of the patient is recommended.
Conflict of Interest
The authors declared no conflict of interest.
Acknowledgments
The authors thank all those who helped them writing this paper. The patient evaluation was performed according to the Declaration of Helsinki principle.
References
- Vidyadhara S SA, Rajasekaran S. Widespread metastases from acinic cell carcinoma of parotid gland. Singapore Med J.. 2007; 48(1):e13-e5.
- Çalışkan B, Korkmaz AN, Henderson R. A rare and unusual case of acinic cell carcinoma of parotid gland evaluated by F-18 FDG PET/CT. Acta Medica Anatolia.. 2014; 3:X-X.
- Al-Otaibi SS, Alotaibi F, Al Zaher Y, Al Zaher N, Dababo MA. High-Grade Transformation (Dedifferentiation) of Acinic Cell Carcinoma of the Parotid Gland: Report of an Unusual Variant. Case Rep Otolaryngol.. 2017; 2017:7296467.
- Al-Zaher N, Obeid A, Al-Salam S, Al-Kayyali BS. Acinic cell carcinoma of the salivary glands: a literature review. Hematol Oncol Stem Cell Ther.. 2009; 2(1):259-64.
- Poutoglidis A, Pateras I, Kokkinou V, Tziolas P. Metastatic acinic cell carcinoma of the parotid gland to the abdominal wall. J Surg Case Rep.. 2019; 2019(4):rjz109.
- Khelfa Y, Mansour M, Abdel-Aziz Y, Raufi A, Denning K, Lebowicz Y. Relapsed Acinic Cell Carcinoma of the Parotid Gland With Diffuse Distant Metastasis: Case Report With Literature Review. J Investig Med High Impact Case Rep.. 2016; 4(4):2324709616674742.
- Sepulveda I, Frelinghuysen M, Platin E, Spencer ML, Urra A, Ortega P. Acinic cell carcinoma of the parotid gland: a case report and review of the literature. Case Rep Oncol.. 2015; 8(1):1-8.
- Yue LE, Samankan S, Liu X, Sharif KF, Everest S, Singh T. Ten patients with high-grade transformation of acinic cell carcinomas: expression profiling of β-catenin and cyclin D1 is useful. Pathology-Research and Practice.. 2020; 216(2):152767.
- Skalova A, Sima R, Vanecek T, Muller S, Korabecna M, Nemcova J. Acinic cell carcinoma with high-grade transformation: a report of 9 cases with immunohistochemical study and analysis of TP53 and HER-2/neu genes. Am J Surg Pathol.. 2009; 33(8):1137-45.
- Stanley RJ, Weiland LH, Olsen KD, Pearson BW. Dedifferentiated acinic cell (acinous) carcinoma of the parotid gland. Otolaryngol Head Neck Surg.. 1988; 98(2):155-61.
- Timon CI, Dardick I. The importance of dedifferentiation in recurrent acinic cell carcinoma. J Laryngol Otol.. 2001; 115(8):639-44.
- Piana S, Cavazza A, Pedroni C, Scotti R, Serra L, Gardini G. Dedifferentiated acinic cell carcinoma of the parotid gland with myoepithelial features. Arch Pathol Lab Med.. 2002; 126(9):1104-5.
- Johnykutty S, Miller CH, Hoda RS, Giampoli EJ. Fine-needle aspiration of dedifferentiated acinic cell carcinoma: Report of a case with cyto-histological correlation. Diagn Cytopathol.. 2009; 37(10):763-8.
- Sentani K, Ogawa I, Ozasa K, Sadakane A, Utada M, Tsuya T. Characteristics of 5015 Salivary Gland Neoplasms Registered in the Hiroshima Tumor Tissue Registry over a Period of 39 Years. J Clin Med.. 2019; 8(5):566.
- Triantafillidou K, Iordanidis F, Psomaderis K, Kalimeras E. Acinic cell carcinoma of minor salivary glands: a clinical and immunohistochemical study. J Oral Maxillofac Surg.. 2010; 68(10):2489-96.
- Seifert G, Brocheriou C, Cardesa A, Eveson JW. WHO International Histological Classification of Tumours Tentative Histological Classification of Salivary Gland Tumours. Pathol Res Pract.. 1990; 186(5):555-81.
- Scherl C, Kato MG, Erkul E, Graboyes EM, Nguyen SA, Chi AC. Outcomes and prognostic factors for parotid acinic cell Carcinoma: A National Cancer Database study of 2362 cases. Oral Oncol.. 2018; 82:53-60.
- Neskey DM, Klein JD, Hicks S, Garden AS, Bell DM, El-Naggar AK. Prognostic factors associated with decreased survival in patients with acinic cell carcinoma. JAMA Otolaryngol Head Neck Surg.. 2013; 139(11):1195-202.
- Zenga J, Parikh AS, Emerick KS, Lin DT, Faquin WC, Deschler DG. Close Margins and Adjuvant Radiotherapy in Acinic Cell Carcinoma of the Parotid Gland. JAMA Otolaryngol Head Neck Surg.. 2018; 144(11):1011-6.
- Zhu S, Schuerch C, Hunt J. Review and updates of immunohistochemistry in selected salivary gland and head and neck tumors. Arch Pathol Lab Med.. 2015; 139(1):55-66.
- Speight PM, Barrett AW. Salivary gland tumours: diagnostic challenges and an update on the latest WHO classification. Diagn Histopathol.. 2020; 26(4):147-58.
- Cheuk W, Chan JK, Ngan RK. Dedifferentiation in adenoid cystic carcinoma of salivary gland: an uncommon complication associated with an accelerated clinical course. Am J Surg Pathol.. 1999; 23(4):465-72.
- Nagao T, Gaffey TA, Kay PA, Unni KK, Nascimento AG, Sebo TJ. Dedifferentiation in low-grade mucoepidermoid carcinoma of the parotid gland. Hum Pathol.. 2003; 34(10):1068-72.
- Nagao T. "Dedifferentiation" and high-grade transformation in salivary gland carcinomas. Head Neck Pathol.. 2013; 7 Suppl 1(1):S37-47.
- Mark HF, Hanna I, Gnepp DR. Cytogenetic analysis of salivary gland type tumors. Oral Surg Oral Med Oral Pathol Oral Radiol Endod.. 1996; 82(2):187-92.
- el-Naggar AK, Abdul-Karim FW, Hurr K, Callender D, Luna MA, Batsakis JG. Genetic alterations in acinic cell carcinoma of the parotid gland determined by microsatellite analysis. Cancer Genet Cytogenet.. 1998; 102(1):19-24.
- Gomez DR, Katabi N, Zhung J, Wolden SL, Zelefsky MJ, Kraus DH. Clinical and pathologic prognostic features in acinic cell carcinoma of the parotid gland. Cancer.. 2009; 115(10):2128-37.
- Lewis JE, Olsen KD, Weiland LH. Acinic cell carcinoma. Clinicopathologic review. Cancer.. 1991; 67(1):172-9.
- Perzin KH, LiVolsi VA. Acinic cell carcinomas arising in salivary glands: a clinicopathologic study. Cancer.. 1979; 44(4):1434-57.
- Liu Y, Su M, Yang Y, Zhao B, Qin L, Han Z. Prognostic Factors Associated With Decreased Survival in Patients With Acinic Cell Carcinoma of the Parotid Gland. J Oral Maxillofac Surg.. 2017; 75(2):416-22.
- Ellis GL, Corio RL. Acinic cell adenocarcinoma A clinicopathologic analysis of 294 cases. Cancer.. 1983; 52(3):542-9.
- Schwentner I, Obrist P, Thumfart W, Sprinzl G. Distant metastasis of parotid gland tumors. Acta Otolaryngol.. 2006; 126(4):340-5.
- Ali S, Bryant R, Palmer FL, DiLorenzo M, Shah JP, Patel SG. Distant Metastases in Patients with Carcinoma of the Major Salivary Glands. Ann Surg Oncol.. 2015; 22(12):4014-9.
- Nichols AC, Chan-Seng-Yue M, Yoo J, Agrawal SK, Starmans MH, Waggott D. A case report and genetic characterization of a massive acinic cell carcinoma of the parotid with delayed distant metastases. Case Rep Oncol Med.. 2013; 2013:270362.
- Parikh AS, Khawaja A, Puram SV, Srikanth P, Tjoa T, Lee H. Outcomes and prognostic factors in parotid gland malignancies: A 10-year single center experience. Laryngoscope Investig Otolaryngol.. 2019; 4(6):632-9.
- Ali SA, Kovatch KJ, Yousif J, Gupta S, Rosko AJ, Spector ME. Predictors of distant metastasis in acinic cell carcinoma of the parotid gland. World J Clin Oncol.. 2020; 11(1):11-9.
- Fang Q, Wu J, Du W, Zhang X. Predictors of distant metastasis in parotid acinic cell carcinoma. BMC Cancer.. 2019; 19(1):475.
- Al-Otaibi SS, Alotaibi F, Al Zaher Y, Al Zaher N, Dababo MA. High-Grade Transformation (Dedifferentiation) of Acinic Cell Carcinoma of the Parotid Gland: Report of an Unusual Variant. Case reports in otolaryngology.. 2017; 2017:7296467.
- Wahlberg P, Anderson H, Biorklund A, Moller T, Perfekt R. Carcinoma of the parotid and submandibular glands--a study of survival in 2465 patients. Oral Oncol.. 2002; 38(7):706-13.
- Miller A, Yap V, Folch E, Ibrahim O. A Case of Parotid Acinar Cell Carcinoma With Metastasis to the Lung. Chest.. 2016; 150(4):811A.
- Vander Poorten V, Triantafyllou A, Thompson LD, Bishop J, Hauben E, Hunt J. Salivary acinic cell carcinoma: reappraisal and update. Eur Arch Otorhinolaryngol.. 2016; 273(11):3511-31.

